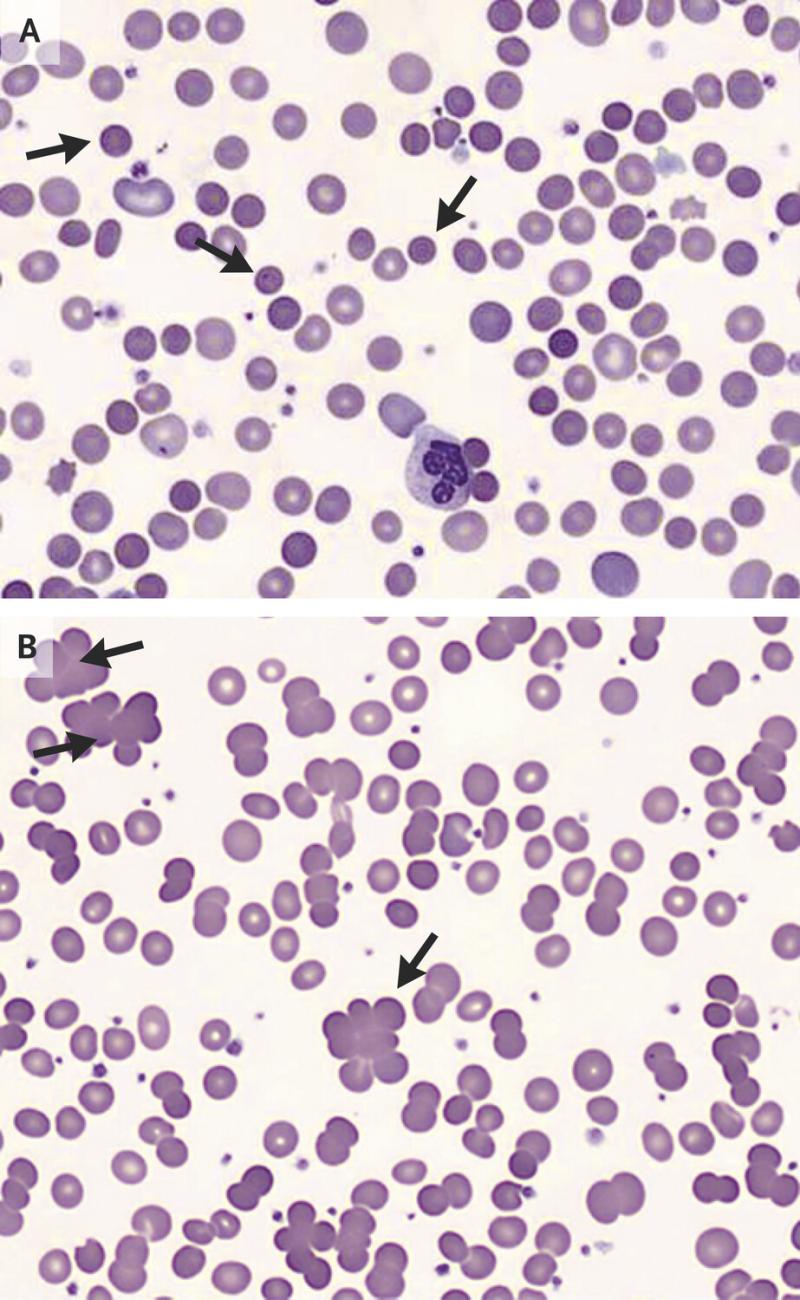

Press release
Warm Autoimmune Hemolytic Anemia Market Growing Rapidly by 2031- Novartis AG, F. Hoffmann-La Roche Ltd, Rigel Pharmaceuticals, Alexion Pharmaceuticals, Inc., Momenta Pharmaceuticals Immunovant, Incyte Corporation
DataM Intelligence has published a new research report on "Warm Autoimmune Hemolytic Anemia Market Size 2024". The report explores comprehensive and insightful Information about various key factors like Regional Growth, Segmentation, CAGR, Business Revenue Status of Top Key Players and Drivers. The purpose of this report is to provide a telescopic view of the current market size by value and volume, opportunities, and development status.Get a Free Sample Research PDF - https://datamintelligence.com/download-sample/warm-autoimmune-hemolytic-anemia-market
The Warm Autoimmune Hemolytic Anemia market report majorly focuses on market trends, historical growth rates, technologies, and the changing investment structure. Additionally, the report shows the latest market insights, increasing growth opportunities, business strategies, and growth plans adopted by major players. Moreover, it contains an analysis of current market dynamics, future developments, and Porter's Five Forces Analysis.
Warm autoimmune hemolytic anemia (wAIHA) is a type of autoimmune disorder characterized by the immune system mistakenly attacking and destroying red blood cells at normal body temperatures (around 37°C or 98.6°F). This condition leads to a decreased number of circulating red blood cells, causing anemia. It is termed "warm" because the antibodies involved in the destruction of red blood cells function optimally at body temperature. Symptoms may include fatigue, pallor, shortness of breath, and jaundice. Treatment typically involves immunosuppressive therapies, corticosteroids, and in some cases, splenectomy or other immune-modulating treatments to manage the underlying autoimmune response and alleviate symptoms.
Forecast Growth Projected:
The Global Warm Autoimmune Hemolytic Anemia Market is anticipated to rise at a considerable rate during the forecast period, between 2024 and 2031. In 2023, the market is growing at a steady rate, and with the rising adoption of strategies by key players, the market is expected to rise over the projected horizon.
List of the Key Players in the Warm Autoimmune Hemolytic Anemia Market:
Novartis AG, F. Hoffmann-La Roche Ltd, Rigel Pharmaceuticals, Alexion Pharmaceuticals, Inc., Momenta Pharmaceuticals Immunovant, Incyte Corporation, Teva Pharmaceutical Industries Ltd, Sanofi, Apellis Pharmaceuticals, Inc and among others.
Segment Covered in the Warm Autoimmune Hemolytic Anemia Market:
By Drug: Class, Immunosuppressive agents, Monoclonal antibodies, Others
By Route of Administration: Oral, Injectable
By Distribution Channel: Hospital Pharmacies, Online Pharmacies, Retail Pharmacies
Regional Analysis:
The global Warm Autoimmune Hemolytic Anemia Market report focuses on six major regions: North America, Latin America, Europe, Asia Pacific, the Middle East, and Africa.
Get Customization in the report as per your requierments: https://datamintelligence.com/customize/warm-autoimmune-hemolytic-anemia-market
Regional Analysis:
The global Warm Autoimmune Hemolytic Anemia Market report focuses on six major regions: North America, Latin America, Europe, Asia Pacific, the Middle East, and Africa. The report offers detailed insight into new product launches, new technology evolutions, innovative services, and ongoing R&D. The report discusses a qualitative and quantitative market analysis, including PEST analysis, SWOT analysis, and Porter's five force analysis. The Warm Autoimmune Hemolytic Anemia Market report also provides fundamental details such as raw material sources, distribution networks, methodologies, production capacities, industry supply chain, and product specifications.
Chapter Outline:
Chapter 1: Introduces the report scope of the report, executive summary of different market segments (by region, product type, application, etc), including the market size of each market segment, future development potential, and so on. It offers a high-level view of the current state of the market and its likely evolution in the short to mid-term, and long term.
Chapter 2: key insights, key emerging trends, etc.
Chapter 3: Manufacturers competitive analysis, detailed analysis of Warm Autoimmune Hemolytic Anemia manufacturers competitive landscape, revenue market share, latest development plan, merger, and acquisition information, etc.
Chapter 4: Provides profiles of key players, introducing the basic situation of the main companies in the market in detail, including product revenue, gross margin, product introduction, recent development, etc.
Chapter 5 & 6: Revenue of Warm Autoimmune Hemolytic Anemia in regional level and country level. It provides a quantitative analysis of the market size and development potential of each region and its main countries and introduces the market development, future development prospects, market space, and market size of each country in the world.
Chapter 7: Provides the analysis of various market segments by Type, covering the market size and development potential of each market segment, to help readers find the blue ocean market in different market segments.
Chapter 8: Provides the analysis of various market segments by Application, covering the market size and development potential of each market segment, to help readers find the blue ocean market in different downstream markets.
Chapter 9: Analysis of industrial chain, including the upstream and downstream of the industry.
Chapter 10: The main points and conclusions of the report.
Get a Free Sample PDF copy of the report @ https://datamintelligence.com/download-sample/warm-autoimmune-hemolytic-anemia-market
Read Latest Blog: https://www.datamintelligence.com/blogs/top-10-process-automation-companies-worldwide
Affiliate Marketing Request here: https://www.datamintelligence.com/affiliate-marketing
Company Name: DataM Intelligence
Contact Person: Sai Kiran
Email: Sai.k@datamintelligence.com
Phone: +1 877 441 4866
Website: https://www.datamintelligence.com
DataM Intelligence is a Market Research and Consulting firm that provides end-to-end business solutions to organizations from Research to Consulting. We, at DataM Intelligence, leverage our top trademark trends, insights and developments to emancipate swift and astute solutions to clients like you. We encompass a multitude of syndicate reports and customized reports with a robust methodology.
Our research database features countless statistics and in-depth analyses across a wide range of 6300+ reports in 40+ domains creating business solutions for more than 200+ companies across 50+ countries; catering to the key business research needs that influence the growth trajectory of our vast clientele.
This release was published on openPR.
Permanent link to this press release:
Copy
Please set a link in the press area of your homepage to this press release on openPR. openPR disclaims liability for any content contained in this release.
You can edit or delete your press release Warm Autoimmune Hemolytic Anemia Market Growing Rapidly by 2031- Novartis AG, F. Hoffmann-La Roche Ltd, Rigel Pharmaceuticals, Alexion Pharmaceuticals, Inc., Momenta Pharmaceuticals Immunovant, Incyte Corporation here
News-ID: 3580002 • Views: …
More Releases from DataM intelligence 4 Market Research LLP
Web Hosting Services Market to Reach US$ 98.8 Billion by 2031, Growing at 21.8% …
Market Overview:
The Global Web Hosting Services Market reached US$ 75.6 billion in 2022 and is expected to reach US$ 98.8 billion by 2031, growing at a CAGR of 21.8% during the forecast period 2024-2031. Demand for web hosting services is projected to rise due to growing awareness of web hosting solutions among internet users. The increasing number of new companies and startups is also likely to boost market growth, as…
United States Newcastle Disease Vaccine Market 2026 | Growth Drivers, Key Player …
Market Size and Growth
Newcastle Disease Vaccine Market is growing at a CAGR of 3.6 % during the forecast period (2024-2031).
Get a Free Sample PDF Of This Report (Get Higher Priority for Corporate Email ID):-https://www.datamintelligence.com/download-sample/newcastle-disease-vaccine-market?sb
Key Development:
United States: Newcastle Disease Vaccine - Industry Developments
✅ In January 2026, researchers published promising results on a recombinant Newcastle Disease Virus (NDV) vaccine offering long-term protection in chickens, highlighting next-gen ND vaccine candidates that could transform…
United States Digestive Health Supplements Market 2026 | Growth Drivers, Key Pla …
Market Size and Growth
The Global Digestive Health Supplements Market is expected to grow at a CAGR of 6.92% during the forecasting period (2024-2031).
Get a Free Sample PDF Of This Report (Get Higher Priority for Corporate Email ID):- https://www.datamintelligence.com/download-sample/digestive-health-supplements-market?sb
Key Development:
United States: Recent Industry Developments
✅ In January 2026, Seed launched an upgraded DS-01 Daily Synbiotic formulation, combining clinically studied probiotic strains with advanced plant-based prebiotics to improve gut balance and digestive resilience.…
United States Bone Morphogenetic Protein Market 2026 | Growth Drivers, Key Playe …
Market Size and Growth
Bone Morphogenetic Protein Market growing with a High CAGR during the forecast period 2024-2031.
Get a Free Sample PDF Of This Report (Get Higher Priority for Corporate Email ID):- https://www.datamintelligence.com/download-sample/bone-morphogenetic-protein-market?sb
Key Development:
United States: Recent Industry & Research Developments
✅ In January 2026, U.S. academic and clinical research centers secured new federal funding to advance BMP-2 delivery technologies for bone regeneration, focusing on controlled release systems to improve safety and therapeutic…
More Releases for Warm
Chinese cinnamon: A fragrant and warm guardian
Cinnamon, a spice and medicinal herb originating from ancient China, has earned the reputation of "King of Fragrances" for its unique aroma and rich medicinal value since ancient times. In traditional Chinese culture, cinnamon [https://www.ruiqiaofoods.com/dried-cinnamon-100-natural-healthy-spice-product/] not only symbolizes auspiciousness, happiness, and warmth, but also has become an indispensable part of people's lives with its profound cultural heritage and practical value.
Cinnamon, also known as cinnamon or official cinnamon, is the dried…
How Big is Warm Water Aquaculture Feed Market?
In 2022, the Global Warm Water Aquaculture Feed Market achieved a value of US$ 4.41 billion. It is projected to escalate to US$ 5.96 billion by 2030, exhibiting a Compound Annual Growth Rate (CAGR) of 3.85% during the forecast period from 2023 to 2030.
This report has a complete table of contents, figures, tables, and charts, as well as insightful analysis. The Warm Water Aquaculture Feed market has been growing significantly…
Warm Autoimmune Hemolytic Anemia (WAIHA) Market
The Global Warm Autoimmune Hemolytic Anemia (WAIHA) Market is projected to exhibit a high CAGR during the forecast period of 2023-2030. WAIHA, which accounts for 60-70% of autoimmune hemolytic anemia (AIHA) cases, is primarily caused by autoantibodies targeting immunoglobulin G (IgG), leading to red blood cell destruction.
Market Dynamics:
Diagnostic Advancements:
Enhanced Laboratory Techniques: Developments in diagnostic laboratory methods, such as flow cytometry and serologic assays, have improved the accuracy and timeliness of…
Warm Slippers Market | Bearpaw, Dearfoams, Hender Scheme, HomeIdeas
Introduction:
The introduction to the report serves as a gateway into the comprehensive world of the warm slippers market. As industries continue to evolve and adapt to changing consumer demands and technological advancements, understanding the market dynamics becomes paramount for industry stakeholders. The report takes on the responsibility of offering a profound and all-encompassing analysis of the warm slippers market, catering to the needs of a diverse audience that includes manufacturers,…
Spring Into Warm Weather With Olive Juice
Children’s Clothing Company Carries Message Of Fun-In-The-Sun
Philadelphia, PA (May 3, 2011) – With spring officially here, the only thing heating up more than the temperature is the fun and fresh looks from children’s apparel line, Olive Juice. From Easter to Memorial Day Weekend, and even Fourth of July, these coming months are all about capturing the fleeting moments of childhood and making lasting memories. Olive Juice has created adorable,…
Kerala Beaches are Warm, Inviting and Sensuous
Kerala the land where nature utters its glory through pristine backwaters, palm fringed beaches, tranquil villages and greenery in profusion. The National Geographic Traveler Magazine named Kerala as one of the ‘Ten Paradises of the World’ and ‘Fifty Places of a Lifetime’. This categorization heightens the glory of Kerala across the globe and make it a hotspot for spending a memorable holidays.
Several mesmerizing destinations of Kerala promise the best…